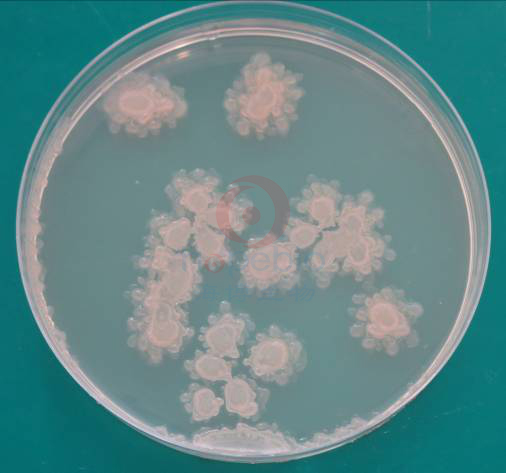

海博微信公众号
海博天猫旗舰店




一、试验原理:
用于嗜热需氧芽孢杆菌的检验。
蛋白胨和牛肉粉提供碳氮源、维生素和生长因子;氯化钠维持均衡的渗透压;琼脂是培养基的凝固剂;硫酸锰可促进芽孢的生成。
二、培养基配方(g/L):
|
硫酸锰 |
0.0308 |
|
蛋白胨 |
10.0 |
|
牛肉粉 |
3.0 |
|
氯化钠 |
5.0 |
|
琼脂 |
15.0 |
|
PH7.2-7.4 |
25℃ |
三、试验方法:
粉体装培养基的使用:
1. 称取本品33.0g,加热溶解于100ml蒸馏水中,121℃高压灭菌15分钟,备用。
2. 必须满足的试验条件:pH值为7.2-7.4
3. 制备质控菌液。
4. 选择合适稀释度的质控菌液0.1ml,均匀涂布于待测平板以及参比平板上,每一稀释度接种两个平板。
5. 55℃倒置培养基培养48小时,记录实验结果。
四、结果观察与解释
接种以下质控菌株,放置28±1℃培养48-96小时。
|
质控菌株 |
菌株编号 |
接种量(CFU) |
生长情况 |
结果 |
|
嗜热脂肪芽孢杆菌 |
ATCC7953 |
10-100 |
TSA |
定量 |
图1-2 锰盐营养琼脂微生物质控结果
五、注意事项
本培养基仅为细菌鉴定的一部分,需做其他补充试验。
相关产品:
注:本文属海博生物原创,未经允许不得转载。
上一篇:副溶血性弧菌琼脂
下一篇:克罗诺菌筛选肉汤培养基原理及使用
| 相关文章: |
